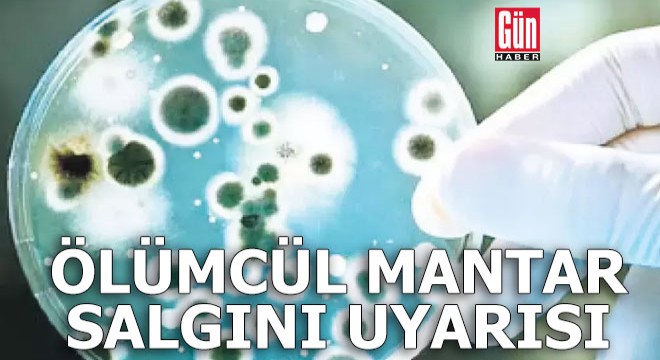

İspanya’da bilim insanları, keşfettikleri “melez” bir mantar türünün daha yüksek sıcaklıklara uyum sağlayacak şekilde evrimleştiğini bildirdi. Deniz ortamında bulunan “Candida ortopsilosis” isimli melez mantarın küresel ısınma nedeniyle “hibridizasyon” adı verilen olayla, iki ebeveyn suştan kaynaklandığı belirtildi.
İLAÇLARA DİRENİYOR
Yeni süper mantar türünün insana enfeksiyon bulaştırma, daha yüksek sıcaklıkta çoğalma ve antifungal ilaçlara direnme gibi özellikler kazandığı ifade edildi. Akademisyen Toni Gabaldon, “Sonuçlarımız hibridizasyonun (genetik işlem) mantarda, insan enfeksiyonuna izin veren özelliklerin hızla kazanılmasına olanak sağladığını gösteriyor. Mantarlarda bu süreç, bizimki gibi bir türü fethetmek için bir kısa yol olabilir” dedi.
(Milliyet)
 |
 |
|||||
|
||||||
 Küfür, hakaret içeren; dil, din, ırk ayrımı yapan; yasalara aykırı ifade ve beyanda bulunan ve tamamı büyük harflerle yazılan yorumlar yayınlanmayacaktır. Neleri kabul ediyorum: IP adresimin kaydedileceğini, adli makamlarca istenmesi durumunda ip adresimin yetkililerle paylaşılacağını, yazılan yorumların sorumluluğunun tarafıma ait olduğunu, yazımın, yetkililerce, fikrim sorulmaksızın yayından kaldırılabileceğini bu siteye girdiğim andan itibaren kabul etmiş sayılırım. |
|
||||||||||||
|
|
||||||||||||
 Koç  21 Mart - 20 Nisan
|
||||||||||||
|
||||||||||||
|
||||||||||||

